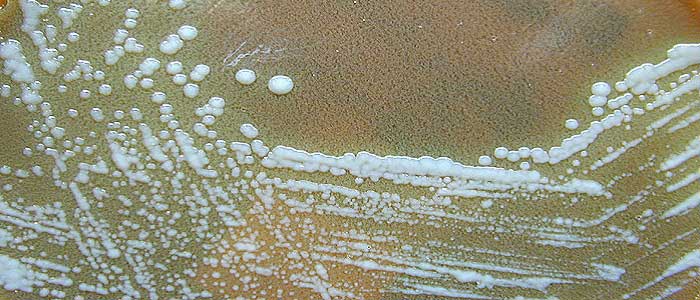
Tularemi Hastalığı Nedir?

Tularemi hastalığı pek bilinmeyen bir hastalık olmakla beraber oldukça ciddi sonuçlara hatta öldürücü etkilere neden olabilen bir rahatsızlıktır. Francisella Tularensis, Latince adı ile Pateurella Tulerensis isimli bakteri tarafından oluşmaktadır. Kemirgenlerde, özellikle tavşan ve sincaplarda öldürücü olan bu hastalığın etken mikro organizması Francisella Tuleransis bakterisidir. Avcı hastalığı veya tavşan ateşi olarak da bilinen bu hastalık, insanlara hayvanlarla direkt temas veya sinek, kene gibi taşıyıcılar vasıtasıyla geçebilmektedir.
Hastalığın kuluçka süresi 3 gündür. Dış tularemi ve iç tularemi olarak ikiye ayrılır. Dış tularemide öncelikle deride kızamık benzeri etkiler gözlenmeye başlar, küçük kabarcıklar zaman içerisinde birleşerek ur şeklini alır.
[renkbox baslik=”Boyun Fıtığı Nedir? Nedenleri, Belirtileri, Korunma Yolları ve Tedavisi” link=”https://www.real.com.tr/boyun-fitigi-nedir/” resim=”https://www.real.com.tr/wp-content/uploads/2017/02/boyun-fitigi-hakkinda-bilgiler.jpg” renk=”mavi” yenisekme=”evet”][/renkbox]
Lenf bezlerinde özellikle bulaşma yerlerine yakın ağrılı şişlikler oluşur. İç tularemide ise, akciğer tüberkülozuna benzeri etkiler gözlenir. İç tulareminin etkileri de cilt üzerinde gözlenir. (Bakınız: Tüberküloz Nedir?)
Tularemi Hastalığı Nedir?
Tularemi, kemirgen hastalığı veya tavşan ateşi olarak da bilinmektedir. İlk olarak 1911 yılında sincaplarda görülmüş ve veba benzeri belirtileri göstermiştir. Özellikle fare, tavşan ve sincap gibi hayvanlar üzerinde öldürücü etkisi bulunmaktadır. Hayvanlara direkt temas ile bulaşabilir. Buna ek olarak temas ettikleri sudan içmek, derilerini çıplak el ile yüzmek, temas ettikleri meyve ve sebzeleri iyice yıkamadan tüketmek, hastalık taşıyan hayvanın etini yeterince pişirmeden tüketmek, hastalık taşıyan sinek veya kene tarafından ısırılmak hastalığın bulaşmasına yeterli olabilen nedenlerdir. Hastalığın insandan insana bulaşmadığı bilinmektedir.
Tularemi, kemirgen hastalığı veya tavşan ateşi olarak da bilinmektedir. İlk olarak 1911 yılında sincaplarda görülmüş ve veba benzeri belirtileri göstermiştir. Özellikle fare, tavşan ve sincap gibi hayvanlar üzerinde öldürücü etkisi bulunmaktadır. Hayvanlara direkt temas ile bulaşabilir. Buna ek olarak temas ettikleri sudan içmek, derilerini çıplak el ile yüzmek, temas ettikleri meyve ve sebzeleri iyice yıkamadan tüketmek, hastalık taşıyan hayvanın etini yeterince pişirmeden tüketmek, hastalık taşıyan sinek veya kene tarafından ısırılmak hastalığın bulaşmasına yeterli olabilen nedenlerdir. Hastalığın insandan insana bulaşmadığı bilinmektedir.
Tularemi Hastalığının Nedenleri Nelerdir?
 Tularemi insandan insana geçmeyen, insanlara hastalık bulunduran hayvanlar veya kene sinek gibi taşıyıcılar aracılığı ile geçen bir hastalıktır. Özellikle de hayvanların temas ettiği suların içilmesi veya teması ile bulaşması en sık görülen yayılma şeklidir. Buna ek olarak, avcı hastalığı olarak bilinmesinin başlıca sebebi hastalık taşıyan hayvanların çıplak elle derileri yüzülmesi ve bu sebeple insana geçmesinin mümkün olmasıdır.
Tularemi insandan insana geçmeyen, insanlara hastalık bulunduran hayvanlar veya kene sinek gibi taşıyıcılar aracılığı ile geçen bir hastalıktır. Özellikle de hayvanların temas ettiği suların içilmesi veya teması ile bulaşması en sık görülen yayılma şeklidir. Buna ek olarak, avcı hastalığı olarak bilinmesinin başlıca sebebi hastalık taşıyan hayvanların çıplak elle derileri yüzülmesi ve bu sebeple insana geçmesinin mümkün olmasıdır.
Tularemi Hastalığının Belirtileri Nelerdir?
 Tularemi hastalığının kuluçka süresi 3 gündür. Hastalığın teşhis edilen en belirgin göstergesi ani şekilde yükselen ateş olarak tanımlanır. Hastalık vücuda girdiği nokta ve bağışıklık siteminin gücüne göre farklı bir seyir izleyebilmektedir. Bazı hastalarda sinsi ve yavaş ilerleyen bir tablo görülmekle beraber, bazı hastalarda ani ilerleme ve ölüme varan sonuçlar söz konusu olmaktadır. Hastalığın genel seyri ani ateşe ek olarak vücutta terleme, aşırı titreme, baş ağrısı ve iştahsızlık olarak gözlenir. Bu duruma boğaz ağrısı ve kesilmeyen bir öksürük eşlik edebileceği gibi aynı zamanda karın ağrısı, bulantı, kusma ve ishal de gözlenebilmektedir. Tularemi hastalığı en sık lenf bezlerini tutar ve burada şişlikler oluşturur.
Tularemi hastalığının kuluçka süresi 3 gündür. Hastalığın teşhis edilen en belirgin göstergesi ani şekilde yükselen ateş olarak tanımlanır. Hastalık vücuda girdiği nokta ve bağışıklık siteminin gücüne göre farklı bir seyir izleyebilmektedir. Bazı hastalarda sinsi ve yavaş ilerleyen bir tablo görülmekle beraber, bazı hastalarda ani ilerleme ve ölüme varan sonuçlar söz konusu olmaktadır. Hastalığın genel seyri ani ateşe ek olarak vücutta terleme, aşırı titreme, baş ağrısı ve iştahsızlık olarak gözlenir. Bu duruma boğaz ağrısı ve kesilmeyen bir öksürük eşlik edebileceği gibi aynı zamanda karın ağrısı, bulantı, kusma ve ishal de gözlenebilmektedir. Tularemi hastalığı en sık lenf bezlerini tutar ve burada şişlikler oluşturur.
Tularemi Hastalığından Korunma Yolları Nelerdir?
 Tularemi hastalığından korunmanın en etkili yolu içme suyu kanallarının çevresel etmenlerden maksimum düzeyde korunacak şekilde inşa edilmesi ve şebeke suyunun deşarj edilmeden önce gerekli analizlerden geçirilmesidir. Şebeke suyunda belediyeler tarafından alınacak önlemlere ek olarak, özellikle kırsal kesimlerde doğada bulunan kaynakların güvenilir ve temizliğine güven olmadığı durumlarda kesinlikle tüketilmemesi gereklidir. Buna ek olarak bir hayvanın tularemi rahatsızlığı dolayısı ile öldüğü tespit edilirse bu mutlaka rapor edilmeli ve o bölgede gerekli görüldüğü durumlarda yani salgın ihtimali öngörülüyorsa hayvanların yok edilmesi gereklidir. Özellikle av hayvanlarının derileri muhakkak ki eldiven ile işleme sokulmalı ve etleri çok iyi derecede pişirildikten sonra tüketilmelidir.
Tularemi hastalığından korunmanın en etkili yolu içme suyu kanallarının çevresel etmenlerden maksimum düzeyde korunacak şekilde inşa edilmesi ve şebeke suyunun deşarj edilmeden önce gerekli analizlerden geçirilmesidir. Şebeke suyunda belediyeler tarafından alınacak önlemlere ek olarak, özellikle kırsal kesimlerde doğada bulunan kaynakların güvenilir ve temizliğine güven olmadığı durumlarda kesinlikle tüketilmemesi gereklidir. Buna ek olarak bir hayvanın tularemi rahatsızlığı dolayısı ile öldüğü tespit edilirse bu mutlaka rapor edilmeli ve o bölgede gerekli görüldüğü durumlarda yani salgın ihtimali öngörülüyorsa hayvanların yok edilmesi gereklidir. Özellikle av hayvanlarının derileri muhakkak ki eldiven ile işleme sokulmalı ve etleri çok iyi derecede pişirildikten sonra tüketilmelidir.
Tularemi Hastalığının Tedavisi Nedir?
 Antibiyotikler aracılığı ile hastaların çoğunda ciddi iyileşmeler gözlenmektedir. Ancak ölüm oranı azaltılmış olsa dahi tularemi tedavisinde hastaların iyileşme süreci bazen aylar geçse dahi sürebilmektedir. Hastalığın iç ilerlemesi gelişmiş ve tanı gecikmişse, lenf bezlerinde oluşacak iltihaplara karşı cerrahi müdahalenin gerekli görüldüğü durumlar mümkündür. Hastalığa müdahalede erken teşhis önemlidir, bu nedenle belirtiler gözlendiğinde mutlaka bir sağlık kuruluşuna başvurulmalıdır.
Antibiyotikler aracılığı ile hastaların çoğunda ciddi iyileşmeler gözlenmektedir. Ancak ölüm oranı azaltılmış olsa dahi tularemi tedavisinde hastaların iyileşme süreci bazen aylar geçse dahi sürebilmektedir. Hastalığın iç ilerlemesi gelişmiş ve tanı gecikmişse, lenf bezlerinde oluşacak iltihaplara karşı cerrahi müdahalenin gerekli görüldüğü durumlar mümkündür. Hastalığa müdahalede erken teşhis önemlidir, bu nedenle belirtiler gözlendiğinde mutlaka bir sağlık kuruluşuna başvurulmalıdır.

